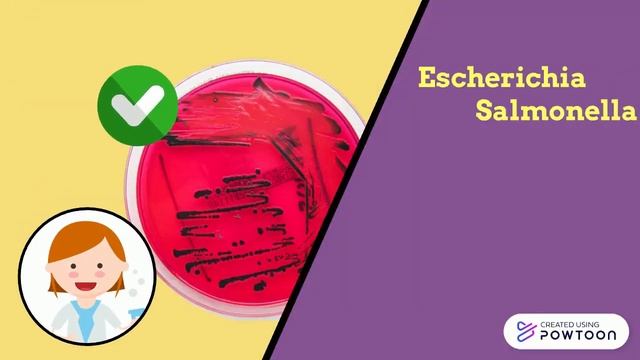
Examples of Fermented Foods смотреть онлайн

Автор / Канал: Радостное исследование Страница 9

70 + Creative Wall shelf design ideas ( Purnima Home Decor) | Home PVC wall Shelves| Creative Ideas

La vita del fumatore: qualche domanda ricorrente.

HONDA WR-V Diesel Malayalam Review

Rajut Sarung Bantal Kursi :: Buat Sarung Bantal Kursi :: Oleh Orang Korea

распаковка 👱♀️сладостей🍭 фууууу... не вкусно😩🌶

Protection and Deprotection of Amine with Mechanism | Protecting Group | Carbamates | Chemistry

🔥FLU INCENDEIA O MERCADO! JORNALISTA CRAVA ATACANTE NO FLU! FULHAM DESISTIU? ANDRÉ FICA?MANO DEFINI

Вся Франция в одном кейсе

ПРОГУЛКА ПО СЛАВЫ, ПЕРЕХОД-"КРАБ", ПАРК ИНТЕРНАЦИОНАЛИСТОВ

Ministry of sound Latino mix cd3
Examples of Fermented Foods

Lova Spintoje Monoidėja

Pedaços de Tempo

How To Make A Lovely Crocheted Heart Doily - DIY Crafts Tutorial - Guidecentral

Зарина жанпеисова барабаны

Stock Car Challenge - Etapa 03 #Forza

気が抜けない⁉ハラハラする子供のお手伝いw【ほのぼの】【ゆっくり解説】

Ms chuhan organic chemistry for #iitneet #studytips @dreamcompetitiveclasses3853

KADI - Led By A Dollar (Official Audio)

Как полюбить себя?Как изменить свою жизнь?💖1 серия

Gereniol Terpenoid by Mukesh Kumar Jangid

3 in 1 WALL RACK, PP VIRGIN PLASTIC QUALITY, T-TWO PLASTIC, T-TWO ENTERPRISE UMARPUR.

PNL // J'SUIS QLF (instru)

Судан 10 киршей 1956 - 1969 / Sudan 10 qirsh 1956 - 1969
За каждым успешным каналом стоит личность, идея и сотни часов кропотливого труда. Если вы здесь, значит, автор «Радостное исследование» уже сумел зацепить ваше внимание своим уникальным стилем или подачей. А мы на RUVIDEO позаботились о том, чтобы вы могли изучить весь архив его работ в максимально комфортных условиях — без лишней суеты и преград.
Почему за работами канала «Радостное исследование» так интересно наблюдать? Всё просто: это честный контент, который находит отклик в сердцах зрителей. На нашем ресурсе вы можете смотреть онлайн все видео любимого автора бесплатно и в хорошем качестве. Нам важно, чтобы вы видели каждую деталь и слышали каждый нюанс, поэтому мы используем только стабильные плееры из открытых источников Rutube.
Следите за новинками канала, пересматривайте старые шедевры и открывайте для себя новые грани творчества «Радостное исследование». Мы постоянно обновляем ленту, чтобы у вас под рукой всегда были самые свежие выпуски. Никаких сложных регистраций — только вы и творчество, которое вдохновляет. Приятного вам путешествия по миру авторского контента на RUVIDEO!
Видео взято из открытых источников Rutube. Если вы правообладатель, обратитесь к первоисточнику.